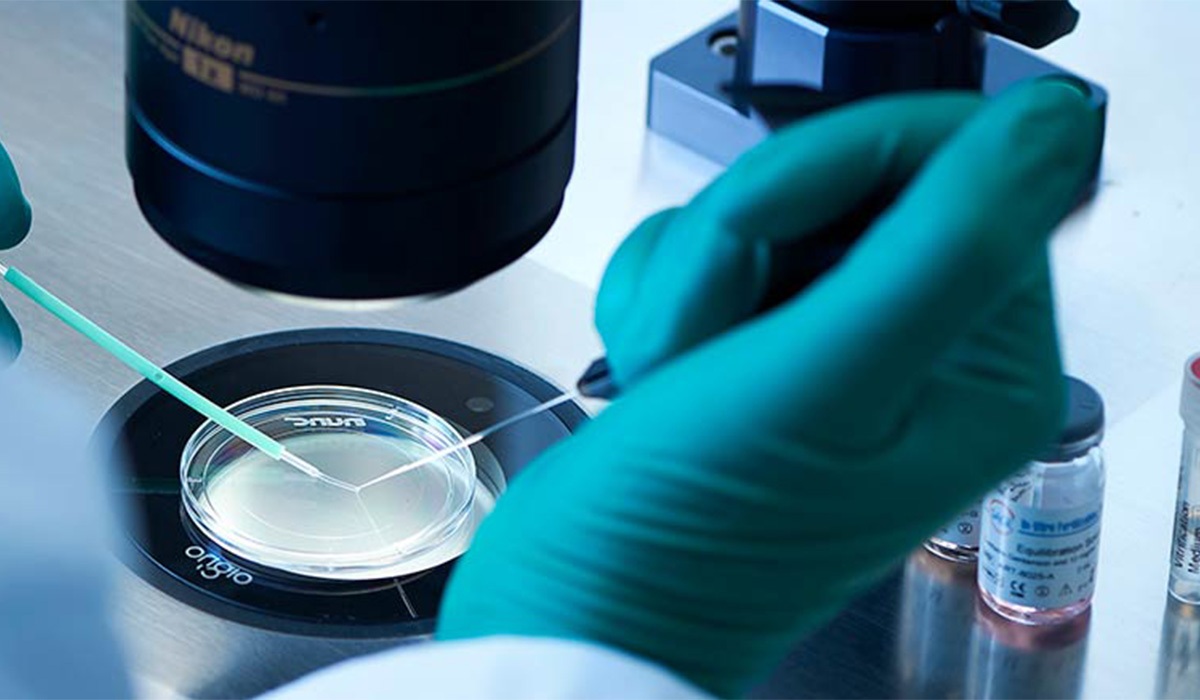
آخرین اخبار از گمشدن جنینها در بیمارستان آبان تهران | بررسی قضایی پرونده آغاز شد جنین فریز شده

آخرین اخبار از گمشدن جنینها در بیمارستان آبان تهران | بررسی قضایی پرونده آغاز شد
رویداد۲۴| معاون درمان وزارت بهداشت با بیان این که جنینهای بیمارستان آبان با هماهنگی صاحبان، به یک مرکز درمانی دیگر منتقل شدهاند، از ارسال پرونده جنینهای بیمارستان آبان به مراجع قضایی خبر داد.
سید سجاد رضوی در گفتوگوییی درباره اخباری مبنی بر گم شدن جنینهای بخش IVF در بیمارستان آبان اظهار کرد: بیمارستان آبان تحت نظر دانشگاه ایران است که این موضوع را به همراه دانشگاه پیگیری کردیم و اطلاعاتی که ما داریم این است که بیمارستان در حال تعطیلی بوده، اما مرکزی که آیویاف انجام میداده، فعال بوده است. با توجه به مشکلاتی که پیش آمده، دانشگاه و وزارتخانه به صورت مشترک موضوع را پیگیری کردهاند.
بیشتر بخوانید: گزارش تکاندهنده از گم شدن جنینها در بیمارستان آبان تهران
وی در پاسخ به این سؤال که آیا جنینها جابجا و یا گم شدهاند؟ افزود: این موضوع در دست بررسی و پرونده در حال تکمیل است و اگر امروز تکمیل شود، به دادسرا ارسال خواهد شد تا در آنجا در مورد وضعیت موجود تصمیمگیری شود.
معاون درمان وزارت بهداشت گفت: در حال حاضر، جنینها با هماهنگی صاحبان، به یک مرکز درمانی دیگر منتقل شدهاند. اگر تخلفی صورت گرفته باشد، تصمیمگیری نهایی با مرجع قضایی خواهد بود.